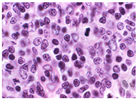
Electronics 12 00651 i001

Segmentation of Nucleus and Cytoplasm from H&E-Stained Follicular Lymphoma
Abstract
1. Introduction
1.1. An introduction to Follicular Lymphoma: A Subtype of NHL
1.2. Histopathological Analysis of Follicular Lymphoma
- Centrocytes typically have cleaved nuclei and appear with an abnormal, stretched shape
- Centroblasts are more giant cells that may have round (non-cleaved) or cleaved nuclei.
- The number of centroblasts per high-power field (HPF) may be counted and used to estimate the severity of the disease.
- CBs frequently have more open chromatin, giving the nucleus a lighter appearance; they can be counted to estimate how aggressive the disease is.
2. Literature Review
3. Proposed Methodology
3.1. Projection of H&E-Stained Image over L*a*b* Color Space
3.2. K-Means Clustering Based Segmentation
- 1-
- Assign each pattern to the closest cluster center, i.e., .
- 2-
- Recompute the cluster centers using cluster memberships.
- 3-
- If convergence criteria are not met, go to step 2 with new cluster centers by the following equation, i.e.,
3.3. Adaptive and Thresholding Function
3.4. Procedure for Boundarization of Each Nucleus
- Pixel intensity will remain constant next to the point as the assumption is a biased field is slowly varying.
- The H&E-stained FL image ( has approximately N separate regions with constant values respectively. So, based on these assumptions and Equation (4), isolating the regions , having constant and the bias field () for inputted FL histology.
- A.
- Minimizing energy with respect to
- B.
- Minimizing energy with respect to
- C.
- Minimizing energy with respect to
4. Results
4.1. Result of Representation of FL Image on L*a*b* Color Space
4.2. Result of k-Means Clustering Algorithm
4.3. Procedure for Boundarization of Each Nucleus
5. Discussion and Comparison with the Previous State of Arts
5.1. Quantitative Evaluation of the Proposed Segmentation Technique
5.2. Independent from the Contour Initialization
6. Conclusions and Future Scope
Author Contributions
Funding
Data Availability Statement
Conflicts of Interest
References
- Siegel, R.L.; Miller, K.D.; Jemal, A. Cancer Statistics. CA Cancer J. Clin. 2021, 71, 7–33. [Google Scholar] [CrossRef]
- National Cancer Institute United State. Cancer Stat Facts: Non-Hodgkin Lymphoma. Available online: https://seer.cancer.gov/statfacts/html/nhl.html (accessed on 30 July 2021).
- Teras, L.R.; DeSantis, C.E.; Cerhan, J.R.; Morton, L.M.; Jemal, A.; Flowers, C.R. 2016 US Lymphoid Malignancy Statistics by World Health Organization Subtypes. CA Cancer J. Clin. 2016, 66, 443–459. [Google Scholar] [CrossRef]
- India Against Cancer; National Institute of Cancer Prevention and Research, Indian Council of Medical Research (ICMR). Available online: http://cancerindia.org.in/ (accessed on 30 July 2021).
- Nair, R.; Arora, N.; Mallath, M.K. Epidemiology of Non-Hodgkin’s Lymphoma in India. Oncology 2016, 91, 18–25. [Google Scholar] [CrossRef]
- Swerdlow, S.; Campo, E.; Harris, N.; Jaffe, E.; Pileri, S.; Stein, T.H.; Vardiman, J. WHO Classification of Tumors of Haematopoietic and Lymphoid Tissues, 4th ed.; World Health Organization: Lyon, France, 2008; Volume 2.
- Hitz; Kettererb, F.; Lohric, A.; Meyd, U.; Pederivae, S.; Rennerf, C.; Tavernag, C.; Hartmannh, A.; Yeowi, K.; Bodisj, S.; et al. Diagnosis and treatment of follicular lymphoma European journal of medical sciences. Swiss Med. Wkly. 2011, 141, w13247. [Google Scholar]
- Samsi, S.; Lozanski, G.; Shanarah, A.; Krishanmurthy, A.K.; Gurcan, M.N. Detection of Follicles from IHC Stained Slide of Follicular lymphoma Using Iterative Watershed. IEEE Trans. Biomed. Eng. 2010, 57, 2609–2612. [Google Scholar] [CrossRef]
- Sertel, O.; Lozanski, G.; Shana’ah, A.; Gurcan, M.N. Computer-aided Detection of Centroblast for Follicular Lymphoma Grading using Adaptive Likelihood based Cell Segmentation. IEEE Trans. Biomed. Eng. 2010, 57, 2613–2616. [Google Scholar] [CrossRef]
- Oztan, B.; Kong, H.; Metin; Gurcan, N.; Yener, B. Follicular Lymphoma Grading using cell-Graphs and Multi-Scale Feature Analysis. In Proceedings of the SPIE Medical Imaging, San Diego, CA, USA, 8–9 February 2012; Volume 83, pp. 345–353. [Google Scholar]
- Gurcan, M.; Boucheron, L.; Can, A.; Madabhushi, A.; Rajpoot, N.; Yener, B. Histopathology Image Analysis: A Review. IEEE Rev. Biomed. Eng. 2009, 2, 147–171. [Google Scholar] [CrossRef]
- Anneke, G.; Bouwer, B.; Imhoff, G.W.; Boonstra, R.; Haralambieva, E.; Berg, A.; Jong, B. Follicular Lymphoma grade 3B includes 3 cytogenetically defined subgroups with primary t(14;18), 3q27, or other translations: T(14;18) and 3q27 are mutually exclusive. Blood J. Hematol. Libr. 2013, 101, 1149–1154. [Google Scholar]
- Mabadhushi, A.; Xu, J. Digital Pathology image analysis: Opportunities and challenges. Image Med. 2009, 1, 7–10. [Google Scholar] [CrossRef]
- Mansoor, A.; Bagci, U.; Foster, B.; Xu, Z.; Papadakis, G.Z.; Folio, R.; Udupa, M.K.; Mollura, D.J. Segmentation and Image Analysis of Abnormal Lungs at CT: Current Approaches, Challenges, and Future Trends. Radiographics 2015, 35, 1056. [Google Scholar] [CrossRef]
- Noor, N.; Than, J.; Rijal, O.; Kassim, R.; Yunus, A.; Zeki, A. Automatic Lung Segmentation Using Control Feedback System: Morphology and Texture Paradigm. J. Med. Syst. 2015, 39, 22. [Google Scholar] [CrossRef] [PubMed]
- Zorman, M.; Kokol, P.; Lenic, M.; de la Rosa, J.L.S.; Sigut, J.F.; Alayon, S. Symbol-based machine learning approach for supervised segmentation of follicular lymphoma images. In Proceedings of the IEEE International Symposium on Computer-Based Medical Systems, Maribor, Slovenia, 20–22 June 2007; pp. 115–120. [Google Scholar]
- Sertel, O.; Kong, J.; Lozanski, G.; Shana’ah, A.; Catalyurek, U.; Saltz, J.; Gurcan, M. Texture classification using nonlinear color quantization: Application to histopathological image analysis. In Proceedings of the IEEE International Conference on Acoustics, Speech and Signal Processing, Las Vegas, NV, USA, 31 March–4 April 2008; pp. 597–600. [Google Scholar]
- Sertel, O.; Kong, J.; Lozanski, G.; Catalyurek, U.; Saltz, J.H.; Gurcan, M.N. Computerized microscopic image analysis of follicular lymphoma. In Proceedings of the Medical Imaging 2008: International Society for Optics and Photonics, San Diego, CA, USA, 17–19 February 2008; Volume 6915, p. 691535. [Google Scholar]
- Yang, L.; Tuzel, O.; Meer, P.; Foran, D.J. Automatic image analysis of histopathology specimens using concave vertex graph. In Proceedings of the Medical Image Computing and Computer-Assisted Intervention, New York, NY, USA, 6–10 September 2008; Volume 11, pp. 833–841. [Google Scholar]
- Sertel, O.; Kong, J.; Catalyurek, U.V.; Lozanski, G.; Saltz, J.H.; Gurcan, M.N. Histopathological image analysis using model-based intermediate representations and color texture: Follicular lymphoma grading. J. Signal Process. Syst. 2009, 55, 169–183. [Google Scholar] [CrossRef]
- Sertel, O.; Catalyurek, U.V.; Lozanski, G.; Shanaah, A.; Gurcan, M.N. An image analysis approach for detecting malignant cells in digitized h&e-stained histology images 475 of follicular lymphoma. In Proceedings of the 20th IEEE International Conference on Pattern Recognition, Istanbul, Turkey, 23–26 August 2010; pp. 273–276. [Google Scholar]
- Belkacem-Boussaid, K.; Prescott, J.; Lozanski, G.; Gurcan, M.N. Segmentation of follicular regions on H&E slides using a matching filter and active contour model. In Proceedings of the SPIE Medical Imaging, International Society for Optics and Photonics, San Diego, CA, USA, 13–18 February 2010; Volume 7624, p. 762436. [Google Scholar]
- Belkacem-Boussaid, K.; Samsi, S.; Lozanski, G.; Gurcan, M.N. Automatic detection of follicular regions in H&E images using iterative shape index. Comput. Med. Imaging Graph. 2011, 35, 592–602. [Google Scholar] [PubMed]
- Kong, H.; Belkacem-Boussaid, K.; Gurcan, M. Cell nuclei segmentation for histopathological image analysis. In Proceedings of the SPIE Medical Imaging: International Society for Optics and Photonics, San Francisco, CA, USA, 22–27 January 2011; p. 79622R. [Google Scholar]
- Kong, H.; Gurcan, M.; Belkacem-Boussaid, K. Partitioning histopathological images: An integrated framework for supervised color-texture segmentation and cell 610 splitting. IEEE Trans. Med. Imaging 2011, 30, 1661–1677. [Google Scholar] [CrossRef]
- Oger, M.; Belhomme, P.; Gurcan, M.N. A general framework for the segmentation of follicular lymphoma virtual slides. Comput. Med. Imaging Graph. 2012, 36, 442–451. [Google Scholar] [CrossRef] [PubMed]
- Saxena, P.; Singh, S.K.; Agrawal, P. A heuristic approach for determining the shape of nuclei from H&E-stained imagery. In Proceedings of the IEEE Students Conference on Engineering and Systems, Allahabad, India, 12–14 April 2013; pp. 1–6. [Google Scholar]
- Michail, E.; Kornaropoulos, E.N.; Dimitropoulos, K.; Grammalidis, N.; Koletsa, T.; Kostopoulos, I. Detection of centroblasts in H&E stained images of follicular lymphoma. In Proceedings of the Signal Processing and Communications Applications Conference, Trabzon, Turkey, 23–25 April 2014; pp. 2319–2322. [Google Scholar]
- Dimitropoulos, K.; Michail, E.; Koletsa, T.; Kostopoulos, I.; Grammalidis, N. Using adaptive neuro-fuzzy inference systems for the detection of centroblasts in microscopic images of follicular lymphoma. Signal Image Video Process. 2014, 8, 33–40. [Google Scholar] [CrossRef]
- Dimitropoulos, K.; Barmpoutis, P.; Koletsa, T.; Kostopoulos, I.; Grammalidis, N. Automated detection and classification of nuclei in pax5 and h&e-stained tissue sections of follicular lymphoma. Signal Image Video Process. 2016, 11, 145–153. [Google Scholar]
- Abas, F.S.; Shana’ah, A.; Christian, B.; Hasserjian, R.; Louissaint, A.; Pennell, M.; Sahiner, B.; Chen, W.; Niazi, M.K.; Lozanski, G.; et al. Computer-assisted quantification of CD3+ T cells in follicular lymphoma. Cytom. Part A 2017, 91, 609–621. [Google Scholar] [CrossRef]
- Syrykh, C.; Abreu, A.; Amara, N.; Siegfried, A.; Maisongrosse, V.; Frenois, F.X.; Martin, L.; Rossi, C.; Laurent, C.; Brousset, P. Accurate diagnosis of lymphoma on whole-slide histopathology images using deep learning. NPJ Digit. Med. 2020, 3, 63. [Google Scholar] [CrossRef]
- Thiam, Y.; Vailhen, N.; Abreu, A.; Syrykh, C.; Frenois, F.; Ricci, R.; Tesson, B.; Sondaz, D.; Gomez, E.; Grivel, A.; et al. Artificial Intelligence Against Lymphoma: A New Deep Learning Based Anatomopathology Assistant to Distinguish Follicular Lymphoma from Follicular Hyperplasia. Eur. Hematol. Assoc. Libr. 2020, 298107, PB2193. [Google Scholar]
- Brousset, P.; Syrykh, C.; Abreu, A.; Amara, N.; Laurent, C. Diagnosis and Classification Assistance from Lymphoma Microscopic Images Using Deep Learning. Hematol. Oncol. 2019, 37, 138. [Google Scholar] [CrossRef]
- Yuan, J.; Wang, D.; Li, R. Remote sensing image segmentation by combining spectral and texture features. IEEE Trans. Geosci. Remote Sens. 2014, 52, 16–24. [Google Scholar] [CrossRef]
- Reska, D.; Boldak, C.; Kretowski, M. A Texture-Based Energy for Active Contour Image Segmentation. In Image Processing & Communications Challenges 6; Springer: Cham, Switzerland, 2015; Volume 313, pp. 187–194. [Google Scholar]
- Wenzhong, Y.; Xiaohui, F. A watershed-based segmentation method for overlapping chromosome images. In Proceedings of the 2nd International Workshop Education Technology Computer Science, Wuhan, China, 6–7 March 2010; Volume 1, pp. 571–573. [Google Scholar]
- Leandro, A.; Fernandes, F.; Oliveira, M. Real-time line detection through an improved Hough transform voting scheme. Pattern Recognit. 2008, 41, 299–314. [Google Scholar]
- Duda, R.; Hart, P. Use of the Hough Transformation to Detect Lines and Curves in Pictures. Graph. Image Process. 1972, 15, 11–15. [Google Scholar] [CrossRef]
- O’Gorman, F.; Clowes, M. Finding picture edges through collinearity of feature points. IEEE Trans. Comput. 1976, 25, 449–456. [Google Scholar] [CrossRef]
- Rizon, M.; Yazid, H.; Saad, P.; Shakaff, A.Y.; Saad, A.R.; Sugisaka, M.; Yaacob, S.; Mamat, M.; Karthigayan, M. Object Detection using Circular Hough Transform. Am. J. Appl. Sci. 2005, 2, 1606–1609. [Google Scholar] [CrossRef]
- Fatakdawala, H.; Xu, J.; Basavanhally, A.; Bhanot, G.; Ganesan, S.; Feldman, M.; Tomaszewski, J.; Madabhushi, A. Expectation maximization driven geodesic active contour with overlap resolution (EMaGACOR): Application to lymphocyte segmentation on breast cancer histopathology. IEEE Trans. Biomed. Eng. 2010, 57, 1676–1689. [Google Scholar] [CrossRef]
- Kass, M.; Witkin, A.; Terzopolos, D. Snakes: Active Contour Models. Int. J. Comput. Vis. 1998, 1, 321–331. [Google Scholar] [CrossRef]
- Madabhushi, A.; Ali, S. An Integrated Region-, boundary-, Shape-Based Active Contour for Multiple Object Overlap Resolution in Histological Imagery. IEEE Trans. Med. Imaging 2012, 31, 1448–1460. [Google Scholar]
- Vese, L.; Chan, T. A multiphase level set framework for image segmentation using the Mumford and Shah model. Int. J. Comput. Vis. 2002, 50, 271–293. [Google Scholar] [CrossRef]
- Chan, T.; Vese, L. Active contours model without edges. IEEE Trans. Image Process. 2001, 10, 266–277. [Google Scholar] [CrossRef]
- Caselles, V.; Kimmel, R.; Sapiro, G. Geodesic active contours. Int. J. Comput. Vis. 1997, 22, 61–79. [Google Scholar] [CrossRef]
- Paragios, N.; Deriche, R. Geodesic active contours and level sets for detection and tracking of moving objects. IEEE Trans. Pattern Anal. Mach. Intell. 2000, 22, 266–280. [Google Scholar] [CrossRef]
- Blake, A.; Isard, M. Active Contours; Springer Society: Cambridge, UK, 1998. [Google Scholar]
- Mohammed, E.A.; Mohamed, M.M.A.; Naugler., C.; Far, B.H. Chronic lymphocytic leukemia cell segmentation from microscopic blood images using watershed algorithm and optimal thresholding. In Proceedings of the Annual IEEE Canadian Conference on Electrical and Computer Engineering, Regina, SK, Canada, 5–8 May 2013; pp. 1–5. [Google Scholar]
- Mumford, D.; Shah, J. Optimal approximations by piecewise smooth functions and associated variational problems. Commun. Pure Appl. Math. 1989, 42, 577–685. [Google Scholar] [CrossRef]
- Chan, T. Level Set Based Shape Prior Segmentation. In Proceedings of the IEEE Computer Society Conference Computation Vision Pattern Recognition, San Diego, CA, USA, 20–25 June 2005; Volume 2, pp. 1164–1170. [Google Scholar]
- Aubert, G.; Kornprobst, P. Mathematical Problems in Image Processing; Partial Differential Equations and the Calculus of Variations; Springer: New York, NY, USA, 2002. [Google Scholar]
- Evans, L. Partial Differential Equations; American Mathematics Society: Providence, RI, USA, 1998. [Google Scholar]














| Reference | Year of Publication | Dataset Used | Region of Interest | Segmentation Approaches |
|---|---|---|---|---|
| [16] | 2007 | Training Set: 3627 Testing Set: 1813 FL images | Isolation of follicular regions | Mean brightness value as a thresholding technique |
| [17] | 2008 | 17 Whole slide FL image | CB and non-CB cells classification | Thresholding to isolate RBC and background followed by K-means clustering |
| [18] | 2008 | 30 IHC Stained Images & 11 H&E-Stained FL images | From IHC-Stained- Follicular region and H&E-Stained centroblast | For detecting follicular region GLCM with S channel from HSV colour model and for CB detection extracted features reduced by PCA and allocation of K-means |
| [19] | 2008 | 18 cases of MCL, 20 cases of CCL, and 9 FL | Overlapping cell nuclei | Last2edges algorithm followed by gradient vector flow algorithm to identify contours. Application of canny edge detector. |
| [20] | 2009 | 17 whole slide images of FL | Isolation of Centroblasts | Thresholding, along with applications of K-means |
| [9] | 2010 | 100 ROI of FL sample | Isolation of Centroblasts | Gaussian mixer model parameterized with expectation maximization. |
| [21] | 2010 | 100 ROI of FL sample | Isolation of Centroblasts | Applications of mean shift elimination technique |
| [22] | 2010 | 40 IHC stained FL images | Follicular region | Active contour Model |
| [23] | 2011 | 15 IHC stained FL images | Follicular region | Region-based image segmentation using curve evolution techniques. |
| [24] | 2011 | 10 FL images | Cellular nuclei | Thresholding followed by local Fourier transformation and application of K-means and KNN |
| [25] | 2012 | 17 FL images | Identification of centroblast | k-means of clustering |
| [10] | 2012 | 12 IHC and H&E- stained FL images | Follicular region | Otsu thresholding and intersection between R plane and B plane binary mask |
| [26] | 2013 | 110 FL images | Follicular region | Application of contour algorithms |
| [27] | 2014 | 12 FL images | Identification of centroblast | Otsu thresholding and LDA to segments nuclei followed by thresholding technique to remove RBCs |
| [28] | 2014 | 300 cells of FL | Centroblast identification | Otsu thresholding |
| [29] | 2014 | 20 FL slide stained with CD20 and H&E | Cytoplasmic element classification | Segmentation by touching cell splitting using GMM classification by the neuro-fuzzy inference system |
| [30] | 2016 | 28 images of FL stained with PAX5 and H&E | Centroblast | k-means clustering and graph cut segmentation procedure |
| [31] | 2017 | H&E-Stained image | Segmentation of CD3+ & CD3-T cells | Entropy-based histogram thresholding |
| [32] | 2019 | H&E-Stained image | Differentiate between FL and follicular hyperplasia | Deep learning-based feature extraction |
| [33] | 2020 | H&E-Stained image | Differentiate between FL and follicular hyperplasia | CNN-based segmentation approaches |
| [34] | 2020 | H&E-Stained image | Differentiate between FL and follicular hyperplasia | Deep learning-based feature extraction |
| Coefficient of Arc Length Term → | Scale Parameter → | 1 | 0.5 | 0.01 | 0.001 | 0.0001 |
|---|---|---|---|---|---|---|
![]() input image | 1 | ![]() | ![]() | ![]() | ![]() | ![]() |
| 2 | ![]() | ![]() | ![]() | ![]() | ![]() | |
| 4 | ![]() | ![]() | ![]() | ![]() | ![]() | |
| 6 | ![]() | ![]() | ![]() | ![]() | ![]() | |
| 8 | ![]() | ![]() | ![]() | ![]() | ![]() |
| Ref. | Type of Staining & Dataset | Object of Interest | Evaluation Result |
|---|---|---|---|
| [16] | detection of follicles by IHC & classification of CB by H&E | classification between CB and non-CB cells | no performance evaluation is done |
| [18] | IHC stain for follicles detection followed by H&E stained for CB cells | classification between CB and non-CB cells | classification accuracy of 90.7% |
| [9] | H&E-Staining & 100 ROI images | CB & non-CB cells classification | Qualitative very high false-positive appealed |
| [21] | H&E-Staining100 ROI of FL images | CB & non-CB cells classification | Maximum accuracy of 80.7% achieved |
| [22] | 436 images of Neoplastic Follicles | CB & non-CB cells classification | 82.57% precision while segmenting |
| [25] | H&E Stained 17 FL images | Detection of nuclei and other cytological components | 87% accuracy in classification |
| [27] | H&E Staining images 0f 180 FL samples | Centroblast detection | 82.58% CB were successfully detected |
| [29] | H&E-Stained images | Cytoplasmic element classification | 90.35% detection rate achieved |
| Proposed k-means based locally formulated energy | 467 H&E-Stained Images | Extraction of Cytoplasmic element | 92% sensitivity |
| Name of Image | Manual Segmentation | Automated Segmentation | ||||
|---|---|---|---|---|---|---|
| Number of CBs | Number of Non-CBs | TP | FP | FN | TN | |
| FL1 | 5 | 3 | 5 | 1 | 0 | 2 |
| FL2 | 6 | 11 | 6 | 1 | 1 | 9 |
| FL3 | 4 | 4 | 3 | 1 | 1 | 3 |
| FL4 | 1 | 12 | 1 | 1 | 0 | 11 |
| FL5 | 8 | 4 | 8 | 0 | 0 | 7 |
| Centroblast | Non-Centroblast | |
|---|---|---|
| Centroblast | True Positive | False Positive |
| Non-centroblast | False Negative | True Negative |
Disclaimer/Publisher’s Note: The statements, opinions and data contained in all publications are solely those of the individual author(s) and contributor(s) and not of MDPI and/or the editor(s). MDPI and/or the editor(s) disclaim responsibility for any injury to people or property resulting from any ideas, methods, instructions or products referred to in the content. |
© 2023 by the authors. Licensee MDPI, Basel, Switzerland. This article is an open access article distributed under the terms and conditions of the Creative Commons Attribution (CC BY) license (https://creativecommons.org/licenses/by/4.0/).
Share and Cite
Saxena, P.; Goyal, A.; Bivi, M.A.; Singh, S.K.; Rashid, M. Segmentation of Nucleus and Cytoplasm from H&E-Stained Follicular Lymphoma. Electronics 2023, 12, 651. https://doi.org/10.3390/electronics12030651
Saxena P, Goyal A, Bivi MA, Singh SK, Rashid M. Segmentation of Nucleus and Cytoplasm from H&E-Stained Follicular Lymphoma. Electronics. 2023; 12(3):651. https://doi.org/10.3390/electronics12030651
Chicago/Turabian StyleSaxena, Pranshu, Anjali Goyal, Mariyam Aysha Bivi, Sanjay Kumar Singh, and Mamoon Rashid. 2023. "Segmentation of Nucleus and Cytoplasm from H&E-Stained Follicular Lymphoma" Electronics 12, no. 3: 651. https://doi.org/10.3390/electronics12030651
APA StyleSaxena, P., Goyal, A., Bivi, M. A., Singh, S. K., & Rashid, M. (2023). Segmentation of Nucleus and Cytoplasm from H&E-Stained Follicular Lymphoma. Electronics, 12(3), 651. https://doi.org/10.3390/electronics12030651